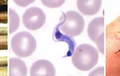
World Chagas Disease Day: WHO calls for early detection for better health - Hindi News | World Chagas Disease Day: WHO calls for early detection for better health | Latest health News at Lokmattimes.com

New Delhi, April 14 The use of skin fairness creams is driving a surge in kidney problems in India, ... ...

![Online food delivery menus missing key nutritional information: Study - Hindi News | Online food delivery menus missing key nutritional information: Study | Latest health News at Lokmattimes.com Online food delivery menus missing key nutritional information: Study - Hindi News | Online food delivery menus missing key nutritional information: Study | Latest health News at Lokmattimes.com]()
New Delhi, April 14 As more and more young people increasingly use apps to make food purchases, a ... ...
![World Chagas Disease Day: WHO calls for early detection for better health - Hindi News | World Chagas Disease Day: WHO calls for early detection for better health | Latest health News at Lokmattimes.com World Chagas Disease Day: WHO calls for early detection for better health - Hindi News | World Chagas Disease Day: WHO calls for early detection for better health | Latest health News at Lokmattimes.com]()
New Delhi, April 14 Early detection of Chagas disease, responsible for 12,000 deaths every year, may help cure ... ...
![Study finds 80 pc microplastics in blood clots behind heart attack, stroke - Hindi News | Study finds 80 pc microplastics in blood clots behind heart attack, stroke | Latest health News at Lokmattimes.com Study finds 80 pc microplastics in blood clots behind heart attack, stroke - Hindi News | Study finds 80 pc microplastics in blood clots behind heart attack, stroke | Latest health News at Lokmattimes.com]()
New Delhi, April 14 A team of scientists in China detected a whopping 80 per cent of microplastics ... ...
![Eat plain yoghurt to lower diabetes risk, combat insulin resistance: Doctors - Hindi News | Eat plain yoghurt to lower diabetes risk, combat insulin resistance: Doctors | Latest health News at Lokmattimes.com Eat plain yoghurt to lower diabetes risk, combat insulin resistance: Doctors - Hindi News | Eat plain yoghurt to lower diabetes risk, combat insulin resistance: Doctors | Latest health News at Lokmattimes.com]()
New Delhi, April 14 Regular consumption of plain yoghurt may help people to reduce their risk of diabetes ... ...
![Indian rural healthcare witnessed significant progress in last decade - Hindi News | Indian rural healthcare witnessed significant progress in last decade | Latest health News at Lokmattimes.com Indian rural healthcare witnessed significant progress in last decade - Hindi News | Indian rural healthcare witnessed significant progress in last decade | Latest health News at Lokmattimes.com]()
New Delhi, April 14 Rural healthcare in India has seen remarkable progress in the last decade, with people ... ...
![Irritable Bowel Syndrome: Why are young adults at high risk? - Hindi News | Irritable Bowel Syndrome: Why are young adults at high risk? | Latest health News at Lokmattimes.com Irritable Bowel Syndrome: Why are young adults at high risk? - Hindi News | Irritable Bowel Syndrome: Why are young adults at high risk? | Latest health News at Lokmattimes.com]()
New Delhi, April 14 Young adults with increased stress in their lives, and who live a sedentary lifestyle ... ...
![Starving cells take over protein transport stations: Study - Hindi News | Starving cells take over protein transport stations: Study | Latest health News at Lokmattimes.com Starving cells take over protein transport stations: Study - Hindi News | Starving cells take over protein transport stations: Study | Latest health News at Lokmattimes.com]()
Maryland [US], April 13 According to a new study, nutrient-starved cells divert protein transport stations to cellular recycling ... ...
![Are animals passing deadly bacteria to humans? - Hindi News | Are animals passing deadly bacteria to humans? | Latest health News at Lokmattimes.com Are animals passing deadly bacteria to humans? - Hindi News | Are animals passing deadly bacteria to humans? | Latest health News at Lokmattimes.com]()
London, April 13 Animals play a role in the spread of deadly bacteria, a new study has revealed. ... ...
![Study gives more insight into molecular causes of different functions of opioid receptors - Hindi News | Study gives more insight into molecular causes of different functions of opioid receptors | Latest health News at Lokmattimes.com Study gives more insight into molecular causes of different functions of opioid receptors - Hindi News | Study gives more insight into molecular causes of different functions of opioid receptors | Latest health News at Lokmattimes.com]()
Leipzig [Germany], April 13 : Drugs that target opioid receptors can have serious adverse effects. Every day, thousands of ... ...